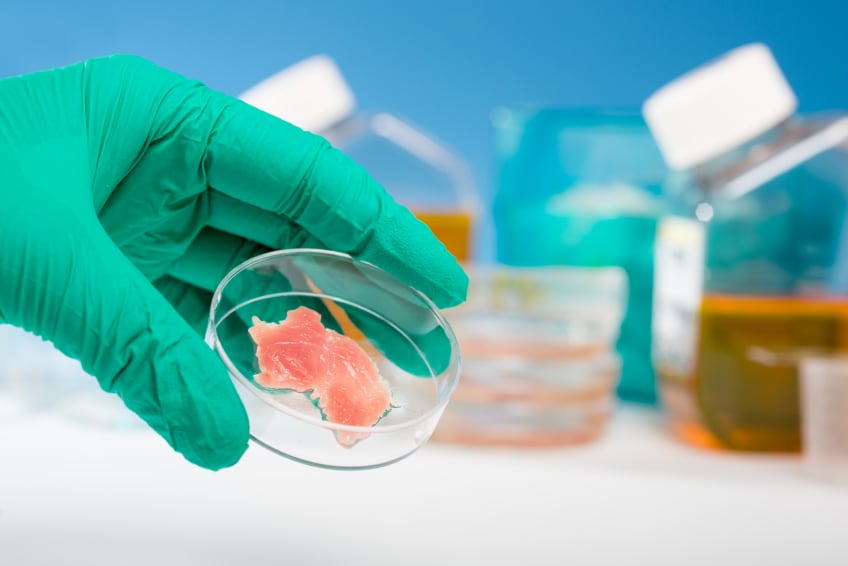

The food industry has seen a jump in deal-making. In the UK alone, food and drink related deals more than doubled in 2017, reaching a value of £21.4bn (€24.2bn) according to figures from Grant Thornton.
And it’s not just trade buyers driving M&A activity: close to a quarter of all F&B transactions (22%) involved private equity firms in 2017 – the highest share on record.
Sanjeev Krishnan, managing director of S2G Ventures, believes this influx of investment, which is driving up multiples, is a somewhat risky game.
“There is a lot of CPG investment on the ingredients side to rebuild your portfolio for growth,” he said at the Future Food Tech conference in London last week. “There is a lot of M&A. The concern is a lot of M&A is acquiring at tech-high multiples.”
Niccolo Manzoni, founding partner of Five Seasons Ventures, agrees that this activity is pushing up valuations – but he does not view this as a barrier to a good deal. “Some of the multiples are crazy. But we try to think, what is the motivation for a corporate? In food, there is a limit to [the size and scale] a start-up can reach. At some point, they will have to have new life in a big corporation”.
In an effort to get around the high price tag for start-ups that have already completed various funding rounds and developed their business models, many CPGs are investing in early stage start-ups, Anton Koehler, MD of Doehler Ventures – the investment arm of Doehler – noted. “Big CPGs are entering start-ups very early. What we would call foot in the door investment.”
So, what are the key trends shaping investment decisions in food?
#1: Brands under pressure
Venture capitalists and strategic investors alike are pumping cash into small and medium sized companies that deliver new solutions and connect with consumers in unique ways.
In the US alone, over the last two years, the top ten food companies have lost $20m in revenue to challenger brands.
"You get small companies that make €10-50m in revenue and when you sum that up, it is billions" - Niccolo Manzoni, Five Seasons Ventures
The influx of investment is partially a response to changing consumer attitudes to brand, which is fragmenting the food and beverage market and placing the market share of large CPG brand owners under pressure.
The typically long innovation pipelines for large corporations – which can take around three years to get a product from concept to market – are a hurdle in today’s fast-paced environment, Tom Espiard, managing partner of Capagro, observed.
“The brand loyalty issue is truly something incumbent or new brands are having to fight for. Trends are emerging fast but fading fast… Growing brand loyalty is really a key issue to reengage with the consumer,” he explained.
#2: ‘You have to get share of heart’
“How to you re-engage? It’s not easy to gain share of basket – you need to gain share of heart. Brands have to move beyond loyalty to relevance. How is it relevant to me, my community, my health?”
Espiard believes that direct consumer is one option to build this relationship – but “it is not the only way”, he added.
For Manzoni, connecting with consumers is paramount for small brands. “At Five Seasons we are really excited about smaller companies being able to sell a story, direct to the consumer,” he revealed.
#3: Appealing to millennials and gen Z

This direct-to-consumer line of sight is vital for food brands to appeal to millennials and generation Z, one of the primary areas that big brand food makers are currently losing out.
According to Doehler’s Koehler reaching out to and engaging with these younger generations is a core priority for the food sector.
“We are an ingredients manufacturer but there is a lot of discussion: How can we reach young consumers… and meet their needs by offering interesting products for them. It is a big problem.”
#4: Digital revolution
Krishnan places the disruption currently taking place in food in the context of the digital revolution that has challenged classical markets over the past 30 years. “The greatest change in market share happens when channels get digitised. That is just starting in food… That to me is what we are watching.”
Krishnan pointed to the rapid growth of e-commerce and an “ecosystem” evolving around direct to consumer marketing as the areas where digital innovation are already making their mark. He expects this trend to accelerate: “The barriers to entry to build brands are going to be coming down even further,” he predicted.
In terms of e-commerce, Manzoni believes that it is important to offer a complete consumer proposition if you are to succeed on a direct-to-consumer basis. “It is very difficult to sell a yogurt [direct to consumer] online because it is not a stand-alone product… Meal kits, meal replacements are moving online. The [other categories] are going to be slower.”
#5: Trust and transparency
Currently, the influence of digital innovation is primarily seen at the sharp end of the supply chain – where brands and retailers interact with consumers. This is only a small proportion of the food chain, however, and investors expect digital innovations to have a transformative impact from farm to fork.
This will be driven by various factors: from the need to make more from fewer resources to increased levels of collaboration that could prove an important engine for innovation.
One of the most pressing factors currently supporting the uptake of digital technologies, such as block chain, is the need to build trust through transparency.
“We are amazed that companies started two years ago enjoy better trust than companies started 150 years ago. That is about quality and story,” Manzoni observed.
One answer is for large CPG companies and retailers to develop stories through a focus on the ingredients they use, how they are sourced, where they are sourced from and any functional benefits they deliver. Transparency down the supply chain can be leveraged to build consumer trust.
#6: Food science: clean meat and personalisation
On the one hand, investment trends in smaller food brands reflect a need to connect with consumers on an “authentic” back-to-basics level. On the other, food tech and science-based innovators are also benefiting from increased investment levels.
“Food science is not to be underestimated. We are seeing a huge shift to food science and we expect that to continue,” Doehler Ventures MD Koehler revealed.
Nadev Berger, founder and managing partner at Peakbridge Partners, agrees. “Food tech is a new industry… It is getting increasing attention and investment. Expecting huge exits is a little early.”
Alongside e-commerce and digital health, Berger sees cellular protein – or clean meat – and growing understanding of the microbiome and human genome as key trends to watch in the future. He predicted that the “complexity” of the latter means it will take “ten years plus” before the food industry is able to offer “true personalisation” based on genetic testing.
Maarten Goossens, co-founder and principal at Anterra Capital, also predicts it will be some time before personalised nutrition is a viable option for the mass market. “True personalisation will take a while because it is so complex,” he suggested.
However, the development of clean meat is closer at hand. “Cellular protein is going to come quicker than you think.”
#7: A ‘protectable moat’
For Krishnan, most brands he would consider investing in need to be “authentic, healthy and functional”. However, he is also looking for a little something extra that differentiates companies from the competition: a “protectable moat”.
This can either come from a supply chain perspective or intellectual property rights. “What we look for is intellectual property or supply chain complexity,” he revealed.
For Manzoni, Five Seasons also believes personality-factor can provide a competitive edge. “What we also look for is marketing talent. Not traditional CPG marketing, gorilla marketing online.”



